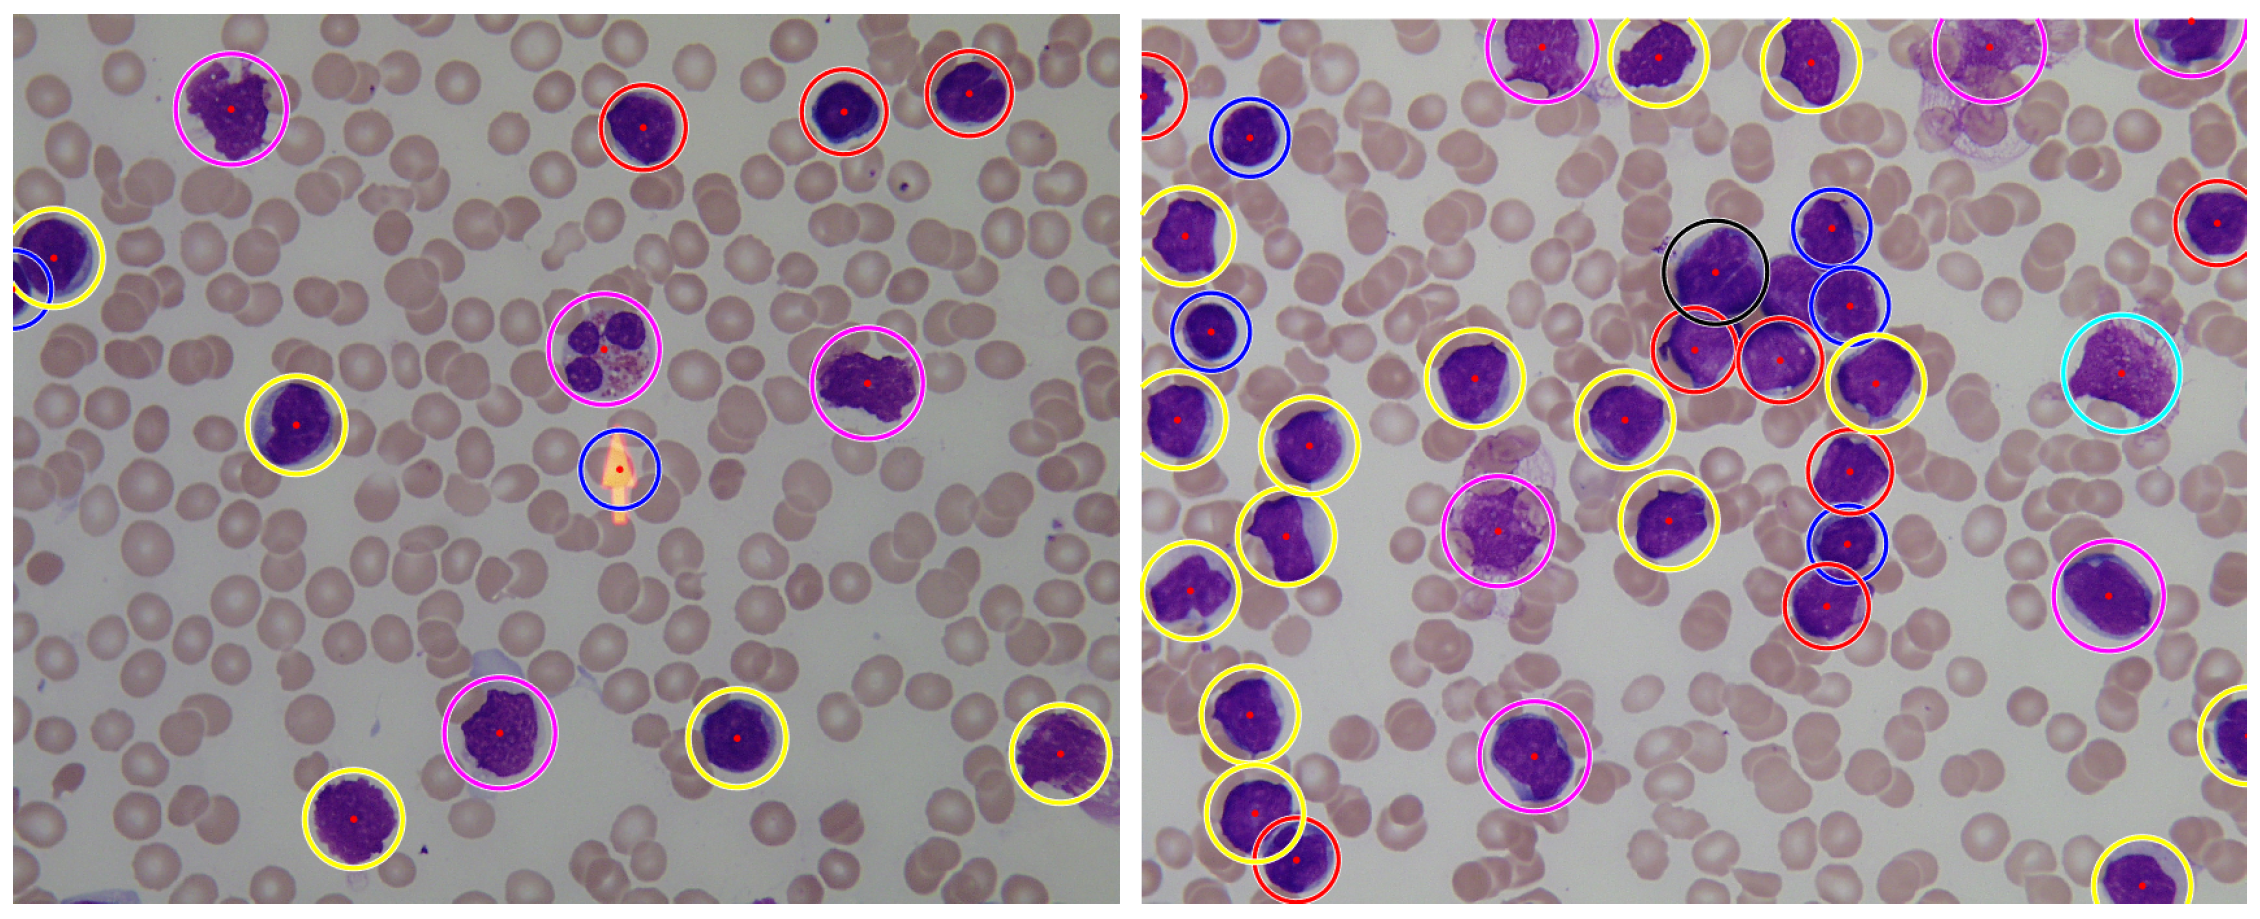
Applsci 10 01176 g015

Blob Detection and Deep Learning for Leukemic Blood Image Analysis
Abstract
1. Introduction
2. Background
3. Related Works
4. Proposed Workflow
- Preprocessing
- Blob detection
- Image segmentation
- Leukocyte recognition
- Leukemia classification
4.1. Preprocessing
4.2. Blob Detection
4.3. Image Segmentation
4.4. Leukocyte Recognition
4.5. Leukemia Classification
5. Experimental Results
5.1. Dataset Description: ALL-IDB
5.2. Dataset Description: SMC-IDB
5.3. Dataset Description: IUMS-IDB
5.4. Results and Comparison with State-of-the-Art
6. Conclusions
Author Contributions
Funding
Conflicts of Interest
Abbreviations
| WBC | White Blood Cell |
| RBC | Red Blood Cell |
| ALL-IDB | Acute Lymphoblastic Leukemia-Image Data Base |
| SMC-IDB | System, Man and Cybernetics-Image Data Base |
| IUMS-IDB | Iran University of Medical Science-Image Data Base |
| MP-IDB | Malaria Parasite Image Data Base |
| TP | True Positive |
| TN | True Negative |
| FN | False Negative |
References
- Erhabor, O.; Adias, T.C. Hematology Made Easy; AuthorHouse: Bloomington, IN, USA, 2013. [Google Scholar]
- Madhloom, H.T.; Kareem, S.A.; Ariffin, H.; Zaidan, A.A.; Alanazi, H.O.; Zaidan, B.B. An automated white blood cell nucleus localization and segmentation using image arithmetic and automatic threshold. J. Appl. Sci. 2010, 10, 959–966. [Google Scholar] [CrossRef]
- Sinha, N.; Ramakrishnan, A.G. Automation of differential blood count. TENCON Conf. Converg. Technol. Asia-Pac. Reg. 2003, 2, 547–551. [Google Scholar]
- Di Ruberto, C.; Putzu, L. Accurate Blood Cells Segmentation through Intuitionistic Fuzzy Set Threshold. In Proceedings of the International Conference SITIS on Signal-Image Technology and Internet-Based Systems, Marrakech, Morocco, 23–27 November 2014; pp. 57–64. [Google Scholar]
- Khan, S.; Khan, A.; Khattak, F.S.; Naseem, A. An accurate and cost effective approach to blood cell count. Int. J. Comput. Appl. 2012, 50, 975–8887. [Google Scholar] [CrossRef][Green Version]
- Putzu, L.; Caocci, G.; Di Ruberto, C. Leucocyte classification for leukemia detection using image processing techniques. AIM 2014, 62, 179–191. [Google Scholar] [PubMed]
- Mahmood, N.H.; Lim, P.C.; Mazalan, S.M.; Razak, M.A.A. Blood cells extraction using color based segmentation technique. Int. J. Life Sci. Biotechnol. Pharma Res. 2013, 2, 233–240. [Google Scholar]
- Alomari, Y.M.; Sheikh Abdullah, S.N.H.; Zaharatul Azma, R.; Omar, K. Automatic detection and quantification of WBCs and RBCs using iterative structured circle detection algorithm. Comput. Math. Methods Med. 2014, 2014, 979302. [Google Scholar] [CrossRef] [PubMed]
- Alilou, M.; Kovalev, V. Automatic object detection and segmentation of the histocytology images using reshapable agents. Image Anal. Stereol. 2013, 32, 89–99. [Google Scholar] [CrossRef]
- Mohapatra, S.; Patra, D.; Satpathy, S. An ensemble classifier system for early diagnosis of acute lymphoblastic leukemia in blood microscopic images. Neural Comput. Appl. 2014, 24, 1887–1904. [Google Scholar] [CrossRef]
- Vincent, I.; Kwon, K.; Lee, S.; Moon, K. Acute lymphoid leukemia classification using two-step neural network classifier. In Proceedings of the 2015 21st Korea-Japan Joint Workshop on Frontiers of Computer Vision (FCV), Mokpo, Korea, 28–30 January 2015; pp. 1–4. [Google Scholar] [CrossRef]
- Singh, G.; Bathla, G.; Kaur, S. Design of new architecture to detect leukemia cancer from medical images. Int. J. Appl. Eng. Res. 2016, 11, 7087–7094. [Google Scholar]
- Vogado, L.H.; Veras, R.M.; Araujo, F.H.; Silva, R.R.; Aires, K.R. Leukemia diagnosis in blood slides using transfer learning in CNNs and SVM for classification. Eng. Appl. Artif. Intell. 2018, 72, 415–422. [Google Scholar] [CrossRef]
- Lindeberg, T. Feature detection with automatic scale selection. Int. J. Comput. Vis. 1998, 30, 77–116. [Google Scholar]
- Meyer, F. Topographic distance and watershed lines. Signal Process. 1994, 38, 113–125. [Google Scholar] [CrossRef]
- Otsu, N. A Threshold Selection Method from Gray-Level Histograms. IEEE Trans. Syst. Man Cybern. 1979, 9, 62–66. [Google Scholar] [CrossRef]
- Krizhevsky, A.; Sutskever, I.; Hinton, G.E. ImageNet Classification with Deep Convolutional Neural Networks. Adv. Neural Inf. Process. Syst. 2012. [Google Scholar] [CrossRef]
- Deng, J.; Dong, W.; Socher, R.; Li, L.J.; Li, K.; Fei-Fei, L. ImageNet: A Large-Scale Hierarchical Image Database. In Proceedings of the 2009 IEEE Conference on Computer Vision and Pattern Recognition, Miami, FL, USA, 20–25 June 2009. [Google Scholar]
- Labati, R.D.; Piuri, V.; Scotti, F. All-IDB: The acute lymphoblastic leukemia image database for image processing. In Proceedings of the 2011 18th IEEE International Conference on Image Processing, Brussels, Belgium, 11–14 September 2011; pp. 2045–2048. [Google Scholar]
- Mohamed, M.; Far, B.; Guaily, A. An efficient technique for white blood cells nuclei automatic segmentation. In Proceedings of the IEEE International Conference on Systems, Man, and Cybernetics (SMC), Seoul, Korea, 14–17 October 2012; pp. 220–225. [Google Scholar]
- Sarrafzadeh, O.; Rabbani, H.; Talebi, A.; Banaem, H.U. Selection of the best features for leukocytes classification in blood smear microscopic images. Proc. SPIE 2014, 9041, 8. [Google Scholar]
- Di Ruberto, C.; Loddo, A.; Putzu, L. A leucocytes count system from blood smear images. Mach. Vis. Appl. 2016, 1–10. [Google Scholar] [CrossRef]
- Bhavnani, L.A.; Jaliya, U.K.; Joshi, M.J. Segmentation and Counting of WBCs and RBCs from Microscopic Blood Sample Images. Int. J. Image Graph. Signal Process. 2016, 8, 32–40. [Google Scholar] [CrossRef]
- Loddo, A.; Putzu, L.; Di Ruberto, C.; Fenu, G. A Computer-Aided System for Differential Count from Peripheral Blood Cell Images. In Proceedings of the International Conference on Signal-Image Technology Internet-Based Systems (SITIS), Naples, Italy, 28 November–1 December 2016; pp. 112–118. [Google Scholar]
- Di Ruberto, C.; Loddo, A.; Putzu, L. Detection of red and white blood cells from microscopic blood images using a region proposal approach. Comput. Biol. Med. 2020, 16, 103530. [Google Scholar] [CrossRef] [PubMed]
- Loddo, A.; Di Ruberto, C.; Kocher, M.; Prod’Hom, G. MP-IDB: The Malaria Parasite Image Database for Image Processing and Analysis. In Processing and Analysis of Biomedical Information, SaMBa 2018; Springer: Cham, Switzerland, 2019; Volume 11379, pp. 57–65. [Google Scholar]

| Mahmood [7] | Alilou [9] | Putzu [6] | Di Ruberto [22] | Bhavnani [23] | Loddo [24] | Di Ruberto [25] | Our Method | |
|---|---|---|---|---|---|---|---|---|
| N images | 10 | Unknown | 33 | 33 | 14 | 33 | 33 | 33 |
| Accuracy | 81% | - | - | 99.2% | 94.2% | - | 98.0% | 99.7% |
| Precision | - | 94% | - | 100% | - | 89.0% | 98.7% | 100% |
| Recall | - | 88% | 92% | 99.2% | - | 98.0% | 99.3% | 99.6% |
| F-measure | - | - | - | 99.6% | - | 93.0% | 98.9% | 99.8% |
© 2020 by the authors. Licensee MDPI, Basel, Switzerland. This article is an open access article distributed under the terms and conditions of the Creative Commons Attribution (CC BY) license (http://creativecommons.org/licenses/by/4.0/).
Share and Cite
Di Ruberto, C.; Loddo, A.; Puglisi, G. Blob Detection and Deep Learning for Leukemic Blood Image Analysis. Appl. Sci. 2020, 10, 1176. https://doi.org/10.3390/app10031176
Di Ruberto C, Loddo A, Puglisi G. Blob Detection and Deep Learning for Leukemic Blood Image Analysis. Applied Sciences. 2020; 10(3):1176. https://doi.org/10.3390/app10031176
Chicago/Turabian StyleDi Ruberto, Cecilia, Andrea Loddo, and Giovanni Puglisi. 2020. "Blob Detection and Deep Learning for Leukemic Blood Image Analysis" Applied Sciences 10, no. 3: 1176. https://doi.org/10.3390/app10031176
APA StyleDi Ruberto, C., Loddo, A., & Puglisi, G. (2020). Blob Detection and Deep Learning for Leukemic Blood Image Analysis. Applied Sciences, 10(3), 1176. https://doi.org/10.3390/app10031176

